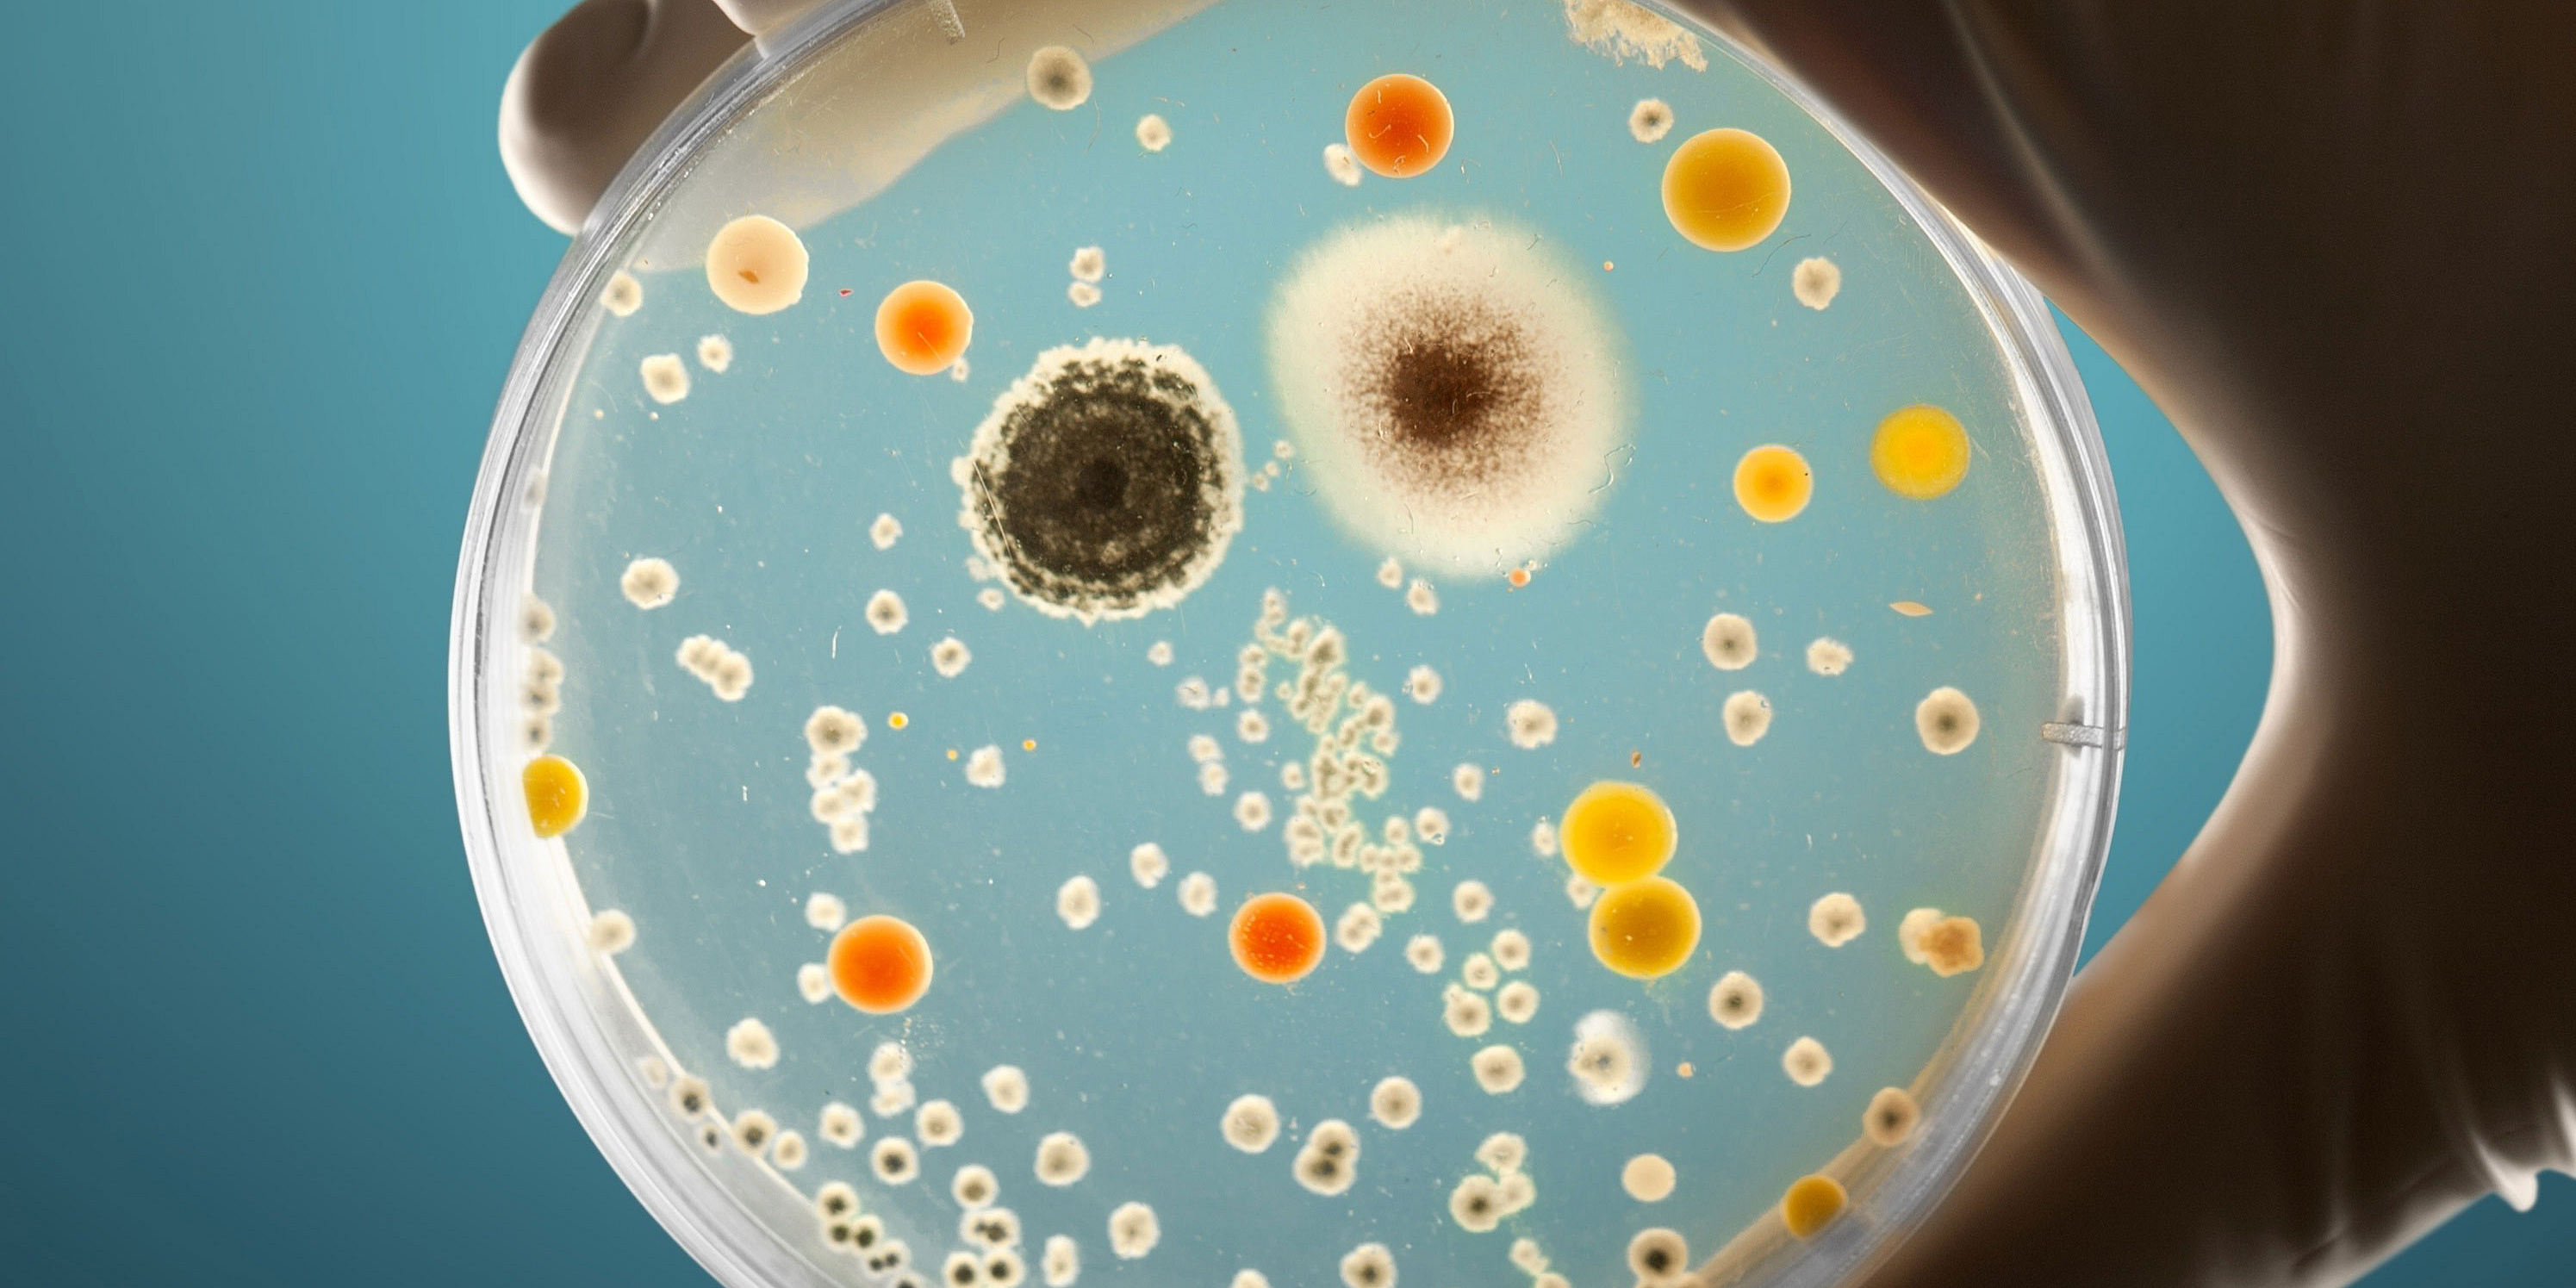
Eine Hand hält eine Petrischale, auf der eine Vielzahl unterschiedlicher Mikroorganismen wachsen

Wachsende Bedrohung bei Pilzbekämpfung
Die Innsbrucker Forscherin Michaela Lackner hat vor zunehmenden Resistenzen gegen Azole, einen zentralen Wirkstoff zur Bekämpfung von Pilzinfektionen, sowie der damit einhergehenden Bedrohung für Mensch, Tier und Umwelt gewarnt. Neben den besser erforschten antibakteriellen Resistenzen würden diese zunehmend zur Gefahr, betonte Lackner im APA-Gespräch. Sie forderte daher die Aufnahme von Antimykotika-Resistenzen in den globalen Aktionsplan gegen antimikrobielle Resistenzen.
"Ziel ist es, die Wirksamkeit der wenigen verfügbaren Medikamente gegen schwere Pilzinfektionen zu erhalten", erklärte die Wissenschafterin der Medizinischen Universität Innsbruck. Mit dem Artikel im Fachmagazin "Nature Medicine" wolle sie gemeinsam mit einem Expert*innenteam zum Thema sensibilisieren und neben den bereits bekannten Antibiotika-Resistenzen stärker auf die wachsende Bedrohung durch Antimykotika-Resistenzen aufmerksam machen. Zudem werde im Mai der sogenannte "Global Action Plan on Antimicrobial Resistance" (GAP-AMR) der Weltgesundheitsorganisation (WHO) für die kommenden Jahre aktualisiert. Die Mykologie, also die Forschung und klinische Versorgung von Pilzinfektionen, sei eine recht junge Disziplin und daher noch nicht in diesem globalen Plan verankert - das soll sich laut Lackner und dem Expertenteam in diesem Jahr ändern.
Eindämmung antimikrobieller Resistenzen
Der aktualisierte GAP-AMR werde anschließend von weiteren weltweit agierenden Organisationen wie der Ernährungs- und Landwirtschaftsorganisation der Vereinten Nationen (FAO), der Weltorganisation für Tiergesundheit (WOAH) sowie vom Umweltprogramm der Vereinten Nationen (UNEP) angenommen. Ein Entwurf des Plans habe bereits gezeigt, dass künftig ein strategischer Fokus auf den verringerten Einsatz von antimikrobiellen Wirkstoffen in Agrar- und Ernährungssystemen sowie einer breiteren Überwachung mithilfe von zusätzlichen Daten gelegt wird. Maßnahmen wie Hygiene oder verbesserte Haltungspraktiken sollten zudem den Bedarf an Antibiotika senken, erklärte die Expertin. Resistenzen könnten dadurch jedenfalls besser eingedämmt werden und eingesetzte Medikamente oder Stoffe für Medizin sowie Landwirtschaft würden ihre Wirksamkeit erhalten.
Pilzinfektionen und die zunehmende Resistenz gegen entsprechende Medikamente seien im Vergleich zu Antibiotika-Resistenzen bisher weniger stark im Fokus gestanden. Dabei würden diese Resistenzen "vom Feld bis hin zur Intensivmedizin" entstehen, sagte die Expertin und verwies auf einen breiten Einsatz in der europäischen Landwirtschaft, aber auch in Human- sowie Veterinärmedizin.
Breiter Einsatz von Azolen in EU
In der Medizin stünden derzeit jedenfalls nur drei Wirkstoffklassen gegen schwere Pilzinfektionen zur Verfügung, erklärte Lackner. Eine davon, die Azole, werde in der Humanmedizin, in der Veterinärmedizin, aber vor allem in der Landwirtschaft eingesetzt. Genau dort liege auch das größte Resistenzproblem, etwa weil der Schimmelpilz Aspergillus fumigatus zunehmend eine Azolresistenz aufbaut. "Pilze weisen in Nordwesteuropa - etwa in Großbritannien oder den Niederlanden - bereits jetzt sehr hohe Azol-Resistenzraten von elf bis 15 Prozent auf", erklärte die Forscherin. In Österreich seien die Werte noch niedriger, da der Einsatz von Fungiziden in der heimischen Landwirtschaft nicht so stark verbreitet ist, vermutete Lackner.
"In Bezug auf die Menge werden mehr als 99 Prozent der Azole in der Landwirtschaft, etwa für den Pflanzenschutz, verwendet", sagte sie. In der Europäischen Union seien in den letzten zehn Jahren jedenfalls rund 120.000 Tonnen Azole oder Azol-haltige Spritzmittel versprüht worden. "Das sind massive Mengen", betont Lackner. Human- und Veterinärmedizin kämen indes gemeinsam nur auf rund 0,2 Prozent. "Es braucht unbedingt ein strikteres Monitoring", forderte die Forscherin. Nötig seien mehr Daten zu Resistenzraten, zum tatsächlichen Fungizideinsatz und zur Belastung der Umwelt.
Zwischen Patientenschutz und Erntesicherung
Weltweit würden Hochrechnungen zufolge jährlich rund 3,75 Millionen Menschen an Pilzinfektionen sterben, erklärte die Forscherin. Betroffen seien vor allem vulnerable Gruppen sowie schwer immungeschwächte Patienten. Wirkende Medikamente sollten jedenfalls geschützt werden, gleichzeitig müsse verhindert werden, dass Pilze immer widerstandsfähiger gegen Arznei- oder auch Spritzmittel werden.
Lackner verwies auf die Bedeutung des Themas für die Landwirtschaft: "Rund 30 Prozent der weltweiten Ernteerträge gehen durch Pilzinfektionen verloren". Aufgerechnet könnte man mit diesen Ernteverlusten jährlich rund 600 Millionen Menschen ernähren, unterstrich sie.
Textnachweis: APA-Science, 15.4.2026
Vonseiten der Med Uni Graz war Martin Hönigl an dem Aufruf beteiligt: „Unsere Forschung hat gezeigt, dass der Klimawandel zu einem wichtigen Treiber für erhöhte Virulenz, die Entwicklung von Thermotoleranz und Antimykotikaresistenz bei Pilzpathogenen wie Aspergillus fumigatus in der Umwelt geworden ist, was wiederum nachteilige Auswirkungen auf gefährdete Patient*innen haben kann, die mit diesen Pilzen in Kontakt kommen", so der Forscher.